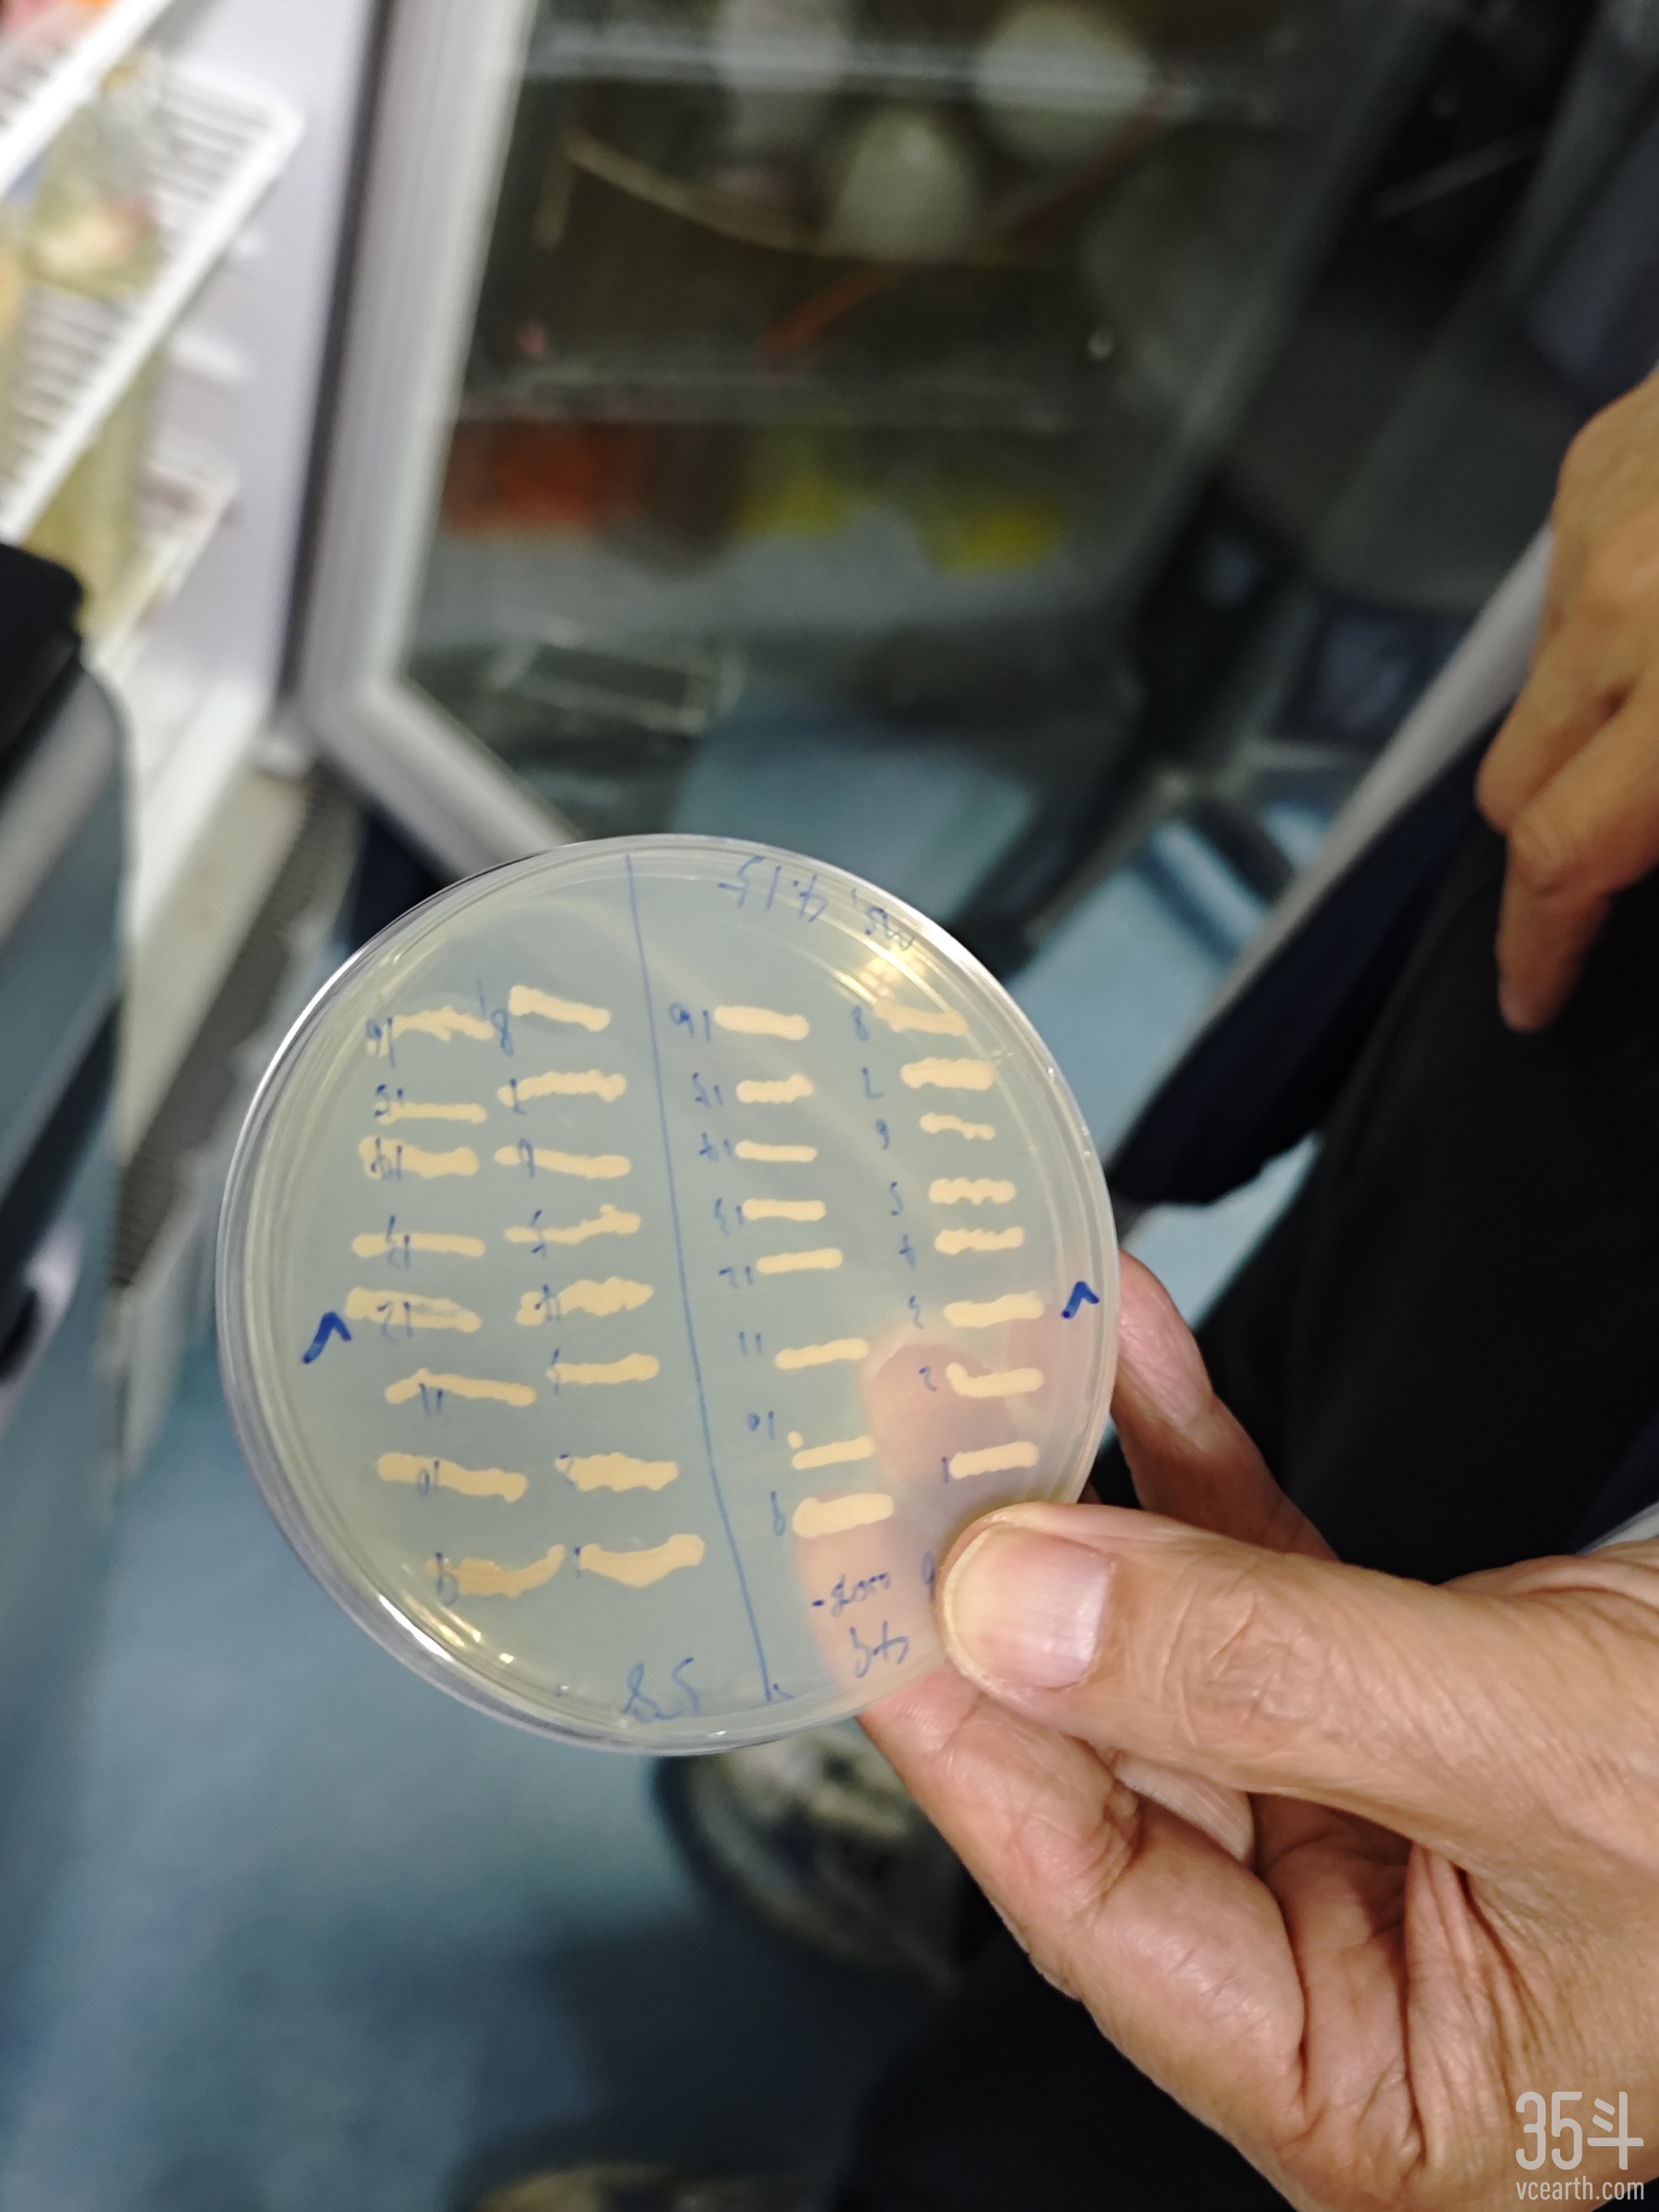

登录35斗
专访清华陈国强:新型工业菌种+“App式”细胞改造,定制合作模式助推生物制造商业落地

陈国强,973“合成生物学”项目首席科学家、教育部长江学者特聘教授,现为清华大学教授、合成与系统生物学中心主任。
18世纪末的英国,机械生产开始替代手工制造,人类开始了漫长的工业制造迭代。穿越三个世纪的进化,生物制造开始萌芽。以菌种、细胞、酶等生命体为载体,利用其生理代谢机能或催化功能,通过工业发酵工艺规模化生产人类所需的化学品和高分子材料、燃料和药品,生物制造正在以指数倍繁殖的速度,逐渐将工业的轰鸣声掩入时代。
清华大学陈国强教授在可降解的PHA生物材料研发上摸索了三十余年,以成功发现高效工业菌种嗜盐菌,并以合成生物学的方式对其研究开发,生产多种PHA(聚羟基脂肪酸酯)和其他小分子化合物的成果,荣获2023年度国际代谢工程奖(IMES Award),成为了获得该荣誉的首位中国大陆科学家。
作为生物制造2.0的推动者,陈国强提出的“下一代工业生物技术(NGIB)”已被业界广泛采用并应用。NGIB选用的底层细胞是从新疆艾丁湖中筛选得到的嗜盐菌,顾名思义,属于极端微生物中的一种,因其能存活于高渗透压盐湖及酸碱条件完全失调的严峻自然环境,嗜盐菌相较于大肠杆菌等传统微生物底盘,有更加出色的皮抗染菌发酵生长能力。
这是由于,多数嗜盐菌同时具有嗜碱性和嗜盐性以及在此条件下高速生长的能力,参照同属于极端微生物中的嗜酸菌和嗜碱菌,两者生长环境中碱性pH值快速生长使其具有较强的抗污染能力。其中,嗜酸菌由于其特殊的耐酸适应机制,也被视为天然的有机酸生产底盘;嗜碱菌则凭借其耐碱适应机制被应用于生产多种化学品和生物燃料,包括利用乙酸、乙醇、乳酸、氢气以及甲烷为原料等。
这样的特质为嗜盐菌防止微生物污染提供了双重屏障。耐受极端pH的嗜盐菌能够通过特殊的机制维持细胞质稳态、避免胞内蛋白质变性,这种特性是大多数其他常见微生物所不具备的。与此同时,相比于利用传统微生物底盘的工业生物技术(CIB),如大肠杆菌等,基于嗜盐菌的NGIB无需灭菌,生产过程可以开放和连续化,降低能源和淡水消耗,且降低生物制造的复杂性和设备的制造成本。
也因此,对嗜盐菌的进一步研究有利于开发新型PJHA材料、酶、蛋白、燃料、药物和化学小分子生产平台,助推其成为下一代工业生物技术潜在的底盘细胞。
图:陈国强向记者展示菌种培养皿
图源:陶薇摄于北京
而嗜盐菌的“发现”也颇具戏剧性。自80年代开始做PHA研究的陈国强,即便探索出了可行的PHA规模化生产方法,也因制造成本、生产流程的复杂性等因素,难以扩大实际生产和应用范围。其中,生物制造成本居高不下的重要原因之一包括反应过程消耗大量淡水和能量,过程复杂却不稳定,染菌率高;而以海水代替淡水,又需要找到合适的生产菌种。
2003年,陈国强团队从新疆大学的古丽老师处得知新疆有一个内陆咸水湖——艾丁湖。在这个世界最酷热、最干燥的地区之一,历经两年的实地考察和筛选,陈国强团队终于成功筛选出适应力最强的工业微生物菌株,也就是嗜盐菌。陈国强团队对嗜盐菌进行多年的代谢工程以及合成生物学改造,下一代工业生物技术(NGIB)是基于嗜盐微生物的节能节水的连续无灭菌开放式工业发酵工艺,能大幅度降低生产成本,更推动了PHA材料的低成本规模化生产。
和团队长年的研究有了积累,陈国强已在如Chemical Reviews、Chemical Society Reviews、Science、Advanced Materials、Advanced Science、Nucleic Acids Research、Nature Communications、Trends in Biotechnology、Biomaterials、Metabolic Engineering 和 Current Opinions in Biotechnology 等国际学术期刊上共发表微生物技术和生物材料相关论文400多篇,Web of Sciences记录论文被引用三万多次(H指数为87)(Google Scholar引用四万多次,H指数100),并已经获得授权专利50多项,以及50个公开专利。
染菌问题随着嗜盐菌的发现而有了眉目,而要令嗜盐菌更适用于大规模生物制造,还需对其进行进一步合成生物学改造。
提及改造过程,陈国强以App开发为例,比喻了对嗜盐菌的合成生物学改造过程。嗜盐菌各种改造技术和方法就像是智能手机上的App,研究团队通过合成生物学的手段,为其编写了全新的“代码”(代谢通路),以便能够生成特定的产物,例如生物塑料PHA。其中,编写代码的过程就是设计一个“生物塑料合成”程序,并巧妙地将其植入到微生物中。
在这个过程中,如果嗜盐菌不遵循指令,不执行生产生物塑料的任务,研究团队就能像管理App的程序员一样,通过设计好的机制来确保其必须完成任务,否则就会面临“生存的挑战”——就像用户如果不希望智能手机上的App运行,可以选择关闭或是直接卸载。
因此,嗜盐菌在这样的改造下,变得像是一个高度定制化的生产工具,专门为研究团队执行特定的任务。微生物内部的代谢通路被精心编辑后,就如同手机用户下载并设置了一个个功能各异的App,让其能够完成从合成生物塑料到各种其他生物产品的多样化任务。据陈国强介绍,其速度能达到半年合成50多种代谢产物。
陈国强团队在论文中指出,团队是从基因工程和代谢工程角度优化提高现有的生物制造效率的。基因工程技术为极端微生物的表达调控奠定了基础,具体方法包括基因表达元件、基因编辑技术以及基因工程方法,其中,多个基因组编辑技术已在下一代工业技术底盘嗜盐菌 Halomonas TD01和众多极端微生物中得到广泛研究。
而陈国强团队的改造工作,就包括重构Halomonas底盘细胞底物代谢途径,使能利用多种底物。此外,还有启动子工程和血红蛋白的配置以及新型搅拌发酵罐,使利用氧气效率大幅提升;重编群体效应代谢通路、形态学工程,改变细菌的生长方式、改造嗜盐菌的表面电荷,使细菌自凝絮,有利于连续发酵和菌分离;开放式的发酵减少了工艺流程和设备的复杂性等,目前该菌株已连续超过40代迭代。

图:陈国强的办公室中陈列多种新材料制成产品
图源:陶薇摄于北京
2021年10月,陈国强带领团队完成200吨发酵罐的PHA开放生产。利用得到的PHA,团队与多个兄弟单位合作,成功制成纤维纺织品、可降解农膜、管材、3D打印材料、医用无纺布以及发光材料等。
不仅如此,在非粮碳源的利用上,陈国强教授团队也屡屡斩获突破。经过改造后的嗜盐菌,可以利用秸秆糖、餐厨废料、废糖蜜、废工业乙酸等原料来合成PHA材料,为农业废弃秸秆的高值利用储备了先进技术,实现了非粮碳源生产。
值得一提的是,2023 年 1 月,工信部等六部门印发《加快非粮生物基材料创新发展三年行动方案》,提出到 2025 年非粮生物质原料利用和应用技术基本成熟,部分非粮生物基产品竞争力与化石基产品相当,高质量、可持续的供给和消费体系初步建立。
而生物质资源利用根据原材料和利用方式的区别,可以划分为三个代际技术迭代。首先是现阶段的主要原料,以粮食作物、淀粉为主,但存在突出的“与粮争地”、“与民争粮”问题;第二阶段的以非粮类产物、木质纤维素、有机生活垃圾等替代传统碳源,但效率和产出都较低。而以无机碳源为原料,需要特殊菌种开发,对光合作用的机制研究待深入,尚待大规模产业化。
不过,以非粮生物质为开发核心的产业,通过不断迭代开发,技术积累已基本完备,将秸秆转化用于较高价值产品开发,成为开启非粮生物质大规模商业应用的关键技术。据陈国强介绍,PHA的碳转化率不高,抬升了制造成本,现在通过合成生物学的办法,试图提高PHA的转化率,下一步研发的重点,即把二氧化碳固定下来转化为PHA。
2022年11月24日,清华大学转化“下一代工业生物技术”创办的合成生物公司“微构工场”与安琪酵母(600298.SH)的合资公司“湖北微琪生物”宣布完成万吨级产线的前期生产工艺验证,首批PHA产品正式下线,即将发往海内外市场。彼时,双方认为当年内能实现量产5000吨供应市场,微构工场和安琪酵母将利用各自的资源和渠道拓展产品销售。
据微琪生物介绍,该项目建成后,基地将成为中国第一、全球第三大的PHA生产基地,位列日本Kaneka和美国Danimer Scientific之后。该基地将是世界上能够生产PHA类型最多的产线,率先量产的产线将生产PHA、PHB和P34HB等混合出的数十种材料。
事实上,在PHA的量产探索中,微构工厂面临的挑战与机遇并存。传统大型企业往往追求规模效益,如酵母等产品的生产已趋近全球产量上限,约为25万吨,显示出市场可能的饱和度。同样,医药行业中的某些产品也面临类似的天花板效应。陈国强指出,团队寻找的正是那些没有产量限制、能够持续扩展的领域,如新材料与生物燃料,它们的需求随着消耗而不断增长,理论上不存在生产上限。与此同时,在追求规模化与成本效益的过程中,“物美价廉”是打开市场无限可能性的关键。当产品足够经济高效时,其产量便不再受传统限制。
量产之路的探索离不开积极合作。2024年初,微构工场与伊犁川宁生物技术股份有限公司(下称川宁生物)达成战略合作,双方将共同出资设立合资公司,重点推动PHA的产业化,双方将率先开启PHA产能合作,利用川宁生物现有产线进行PHA的生产,向全球客户提供不低于2000吨/年的高职值PHA原料,以满足市场需求。
宜昌作为微构工厂另一重要生产基地,也因其优越的生产要素和便捷的物流条件,提供了发展空间。2023年6月3日,位于湖北宜昌的微构工场年产3万吨合成生物PHA可降解材料绿色智能制造项目正式启动动工。这是微构工场创新发展路上的又一里程碑,标志着微构工场再次实现了从科研成果到产品产业化全链条的突破,合成生物“智造”能力迈入全新阶段。
陈国强还提到,微构工厂尤为重视与下游客户的深度合作,并采取一种“定制化”的合作模式,即在合作企业附近建立生产基地,实现产品的即时供应,从而大幅降低运输成本,提高整体运营效率,以求在环保、地膜、包材等方向上寻找突破。

图:陈国强向记者展示新材料制成的膜产品
图源:陶薇摄于北京
“针对新材料的应用,我们发现了一个关键问题。即便我们成功研发出新材料,下游客户往往对其应用场景一无所知。因此,我们组建了一支专业的材料应用团队,通过示范项目(demonstration)和模板展示,帮助客户理解并采纳这些新材料。”
目前,微构工厂已能够开发出符合品牌SDG(可持续发展目标)承诺的减碳减排、环保材料,以及针对农业地膜等特定需求的可降解材料。这些材料不仅性能优越,还能根据使用周期调整性状,满足多样化的市场需求。
工业制造发展三个世纪至今,已历经三次革命。自20世纪四五十年代以来,在原子能、电子计算机、微电子技术、航天技术、分子生物学和遗传工程等领域的爆破之声在进入新时代之后持续回响。
第四次工业革命以系统科学的兴起到合成与系统生物科学的形成为标志,形成系统生物科学与技术体系,包括系统生物学与合成生物学、系统遗传学与系统生物工程、系统医学与系统生物技术等学科体系,将导致的是转化医学、生物工业的产业革命。
陈国强的研究始于系统生物科学正式破土前夜,在摸索近40年后终于实现持续突破。在合成生物学和“下一代工业生物技术”制造PHA生物塑料的道路上,陈国强团队使我国处于世界领先的水平。

图:陈国强畅聊科研的魅力在于它永无止境的探索
图源:陶薇摄于北京
对于自己投入了半生的科研生涯,陈国强说:“科研的魅力在于它永无止境的探索,你总是觉得前方有新的领域等待发掘,即便已有的成果已相当不错,但总能发现还有更优化的空间。这种不断前行的过程,让科研充满了新鲜感。”
注:文中如果涉及35斗记者采访的数据,均由受访者提供并确认。
声明:35斗所刊载内容之知识产权为35斗及相关权利人专属所有或持有。转载请联系gao.kp@vcbeat.net。
用户
反馈